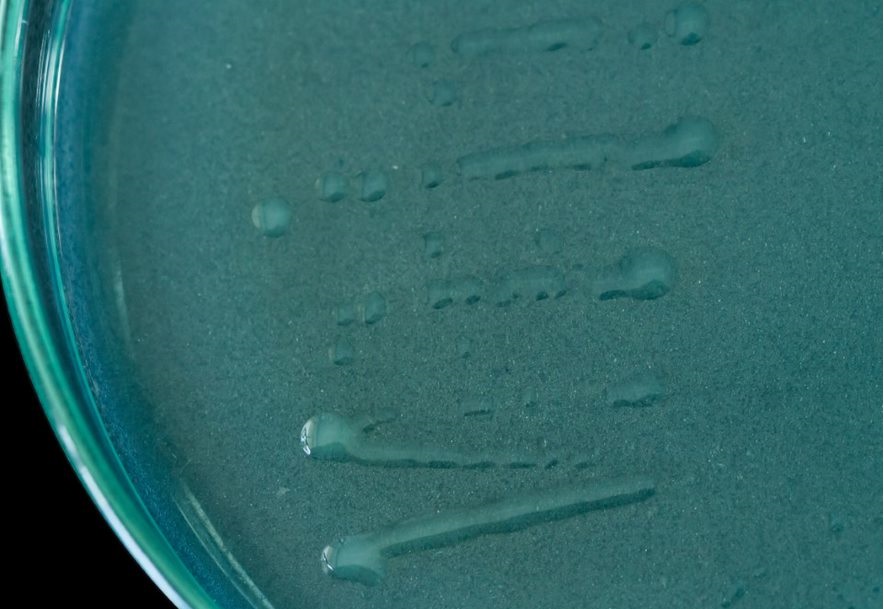

Agrobacterium sp. C289 (AC1)
MORFOLOGÍA
Tamaño colonia (mm): 1 Formación de ácido o álcali: N/A Tiempo de crecimiento: 48 h Color de colonia: Traslúcida en medio LG Transparencia: Trasparente Elevación: Convexa Forma de la colonia: Circular Borde: Entero Formación moco: Positivo |
Imagen macro de “Agrobacterium sp.” en medio de cultivo “LG”. Fuente: Colección Grupo Sistemas Agropecuarios Sostenibles. AGROSAVIA.
Imagen Microscópica de “Agrobacterium sp.” de morfología Bacilar Gram negativa.

Gram de “Agrobacterium sp.”. Fuente: Colección Grupo Sistemas Agropecuarios Sostenibles. AGROSAVIA.
Asignación taxonómica ( ¿ Quién es ?)

La cepa pertenece al género Rhizobium (p-value: 0.024), sin embargo, es probable que no pertenezca a ninguna especie representada en NCBI ya que la especie más cercana es R. pusense con valor ANI del 87,58% y un genoma compartido de 74,62%.
Descripción genómica (¿Qué contiene?)
El genoma de la cepa AC1 tiene un tamaño de 5 Mpb, codificando aproximadamente 4760 proteínas, de las cuales 12 codifican para genes característicos de procesos de solubilización de fósforo, 14 para procesos de fijación de nitrógeno, 8 para producción de índoles, 63 para producción fitohormonas, 33 para actividad ACC-desaminasa y 92 de ellos pertenecen a ciclo del nitrógeno (Tu et al., 2018).
¿Qué puede hacer como biofertilizante?
Respuesta Fisiológica a la Fertilización por Azotobacter chroococcum AC1 y Fertilización Nitrogenada de Síntesis Sobre el Maíz (Zea mays L.) en Invernadero VER DETALLE
Desarrollo de un sistema de fermentación líquida y de enquistamiento para una bacteria fijadora de nitrógeno con potencial como biofertilizante VER DETALLE
Disponibilidad de nutrientes
9,3 µmol C 2 H 2 / mol C 2 H 4
-Fosfato de Hierro
+
-Fosfato de Aluminio
+
Potasio: Solubilización de potasio
-
Producción de sideróforos
-
Producción de hormonas de crecimiento vegetal
15,9 ± 0,2 mg AIA / mL
Producción de exopolisacáridos (EPS)
+
AGROSAVIA reconoce a Colombia como fuente y origen de información genética y/o química publicada aquí. El Estado Colombiano es titular de los recursos genéticos (incluyendo, pero sin limitarse a los recursos biológicos, recursos genéticos, datos genéticos, las secuencias digitales genéticas como expresión digital del recurso genético, genotipado, micromatrices, las proteínas virales y productos derivados), de acuerdo con lo dispuesto en el convenio de la diversidad biológica, el protocolo de Nagoya y la Decisión Andina 391. Su uso y aprovechamiento con potencial de bioprospección, aprovechamiento industrial y aprovechamiento comercial, obtenida del acceso a los recursos genéticos y sus productos derivados, se deberá previamente solicitar autorización al Ministerio de Ambiente y Desarrollo Sostenible de la Nación Colombiana.
Esta información se depositará en una base de datos de consulta, más sin embargo su uso y aprovechamiento tendrá que ser solicitado al MADS.
Cualquier inquietud por favor comuníquese al correo: recursosbiologicos@agrosavia.co